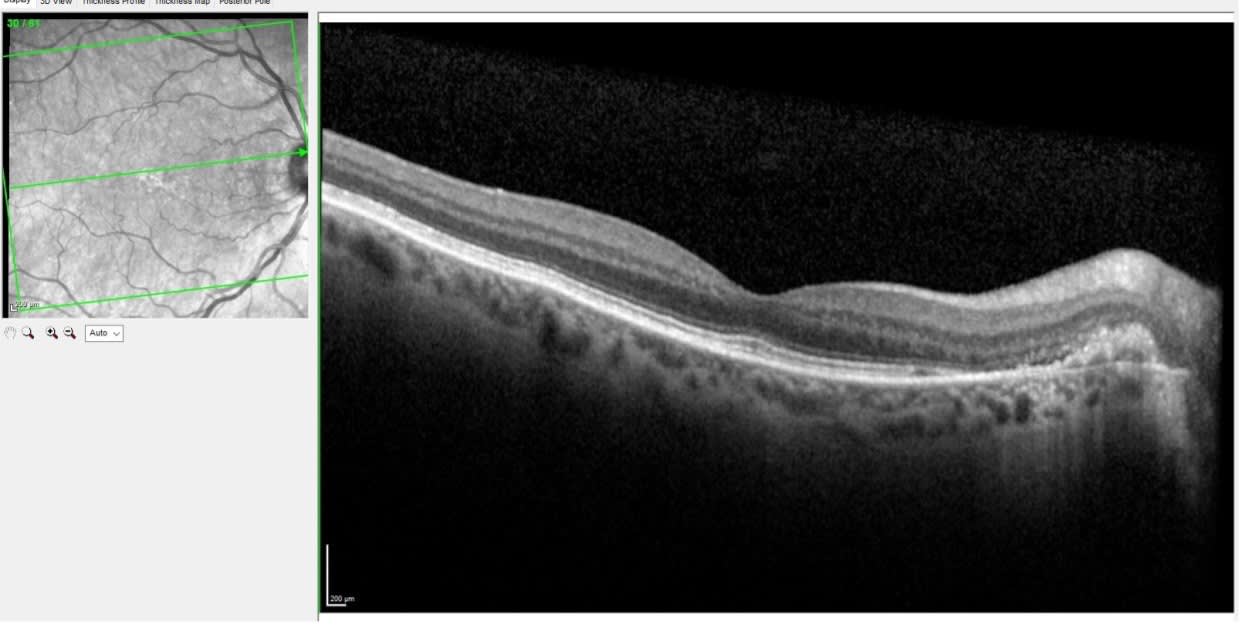

This article was originally published in a sponsored newsletter.
In my clinic, I see a disproportionate number of older individuals, most of whom have chronic ocular diseases that require periodic surveillance. By far, glaucoma and macular degeneration are the two most common conditions I see on a daily basis.
Some patients’ ocular health is relatively benign and they simply need to be monitored every year. It is actually a good break in a busy patient care day when I have a relatively noncomplicated case! But sometimes, patients will throw a curve ball at me and present to clinic with something that I did not suspect previously, as is the case here.
This pleasant 76-year-old Caucasian female has been a patient for many years. She underwent cataract extraction about three years before this visit and was correctable to 20/25 OD, OS and OU. She had some mild macular pigmentary changes that were consistent with her age and visual acuity.
When she presented for her scheduled visit, she essentially had no complaints. As a part of her examination, we obtained macular OCT scans, along with wide-angle multicolor images of both fundi. Figures 1 and 2 below show the right and left fundi from this visit.


Figures 1 and 2 show this patient’s relatively healthy macular appearance, with low suspicion for significant worsening of age-related macular changes. However, also note the area of the right retina adjacent to the optic nerve primarily where the papillomacular bundle originates in Figure 1. This area has slight elevation that is best seen in vivo at the slit lamp. Other than that subtle finding, the posterior poles in both eyes look unremarkable.
However, OCT scanning of the right macula told a different story, as seen in Figure 3.
On close examination of the OCT in the right eye, there is elevation of the neurosensory retina adjacent to the optic nerve, along with disruption of the retinal pigment epithelium (RPE) in this area, and sub-RPE turbid fluid. This finding is consistent with a peripapillary choroidal neovascular membrane.
When we are in the groove of delivering patient care, especially with patients like this, it is easy to only look at the macula for AMD and at the optic nerve for signs of glaucoma or other optic neuropathies. A quick look in vivo at both areas could have easily missed the subtle elevation of the perioptic retina temporally, but seeing this abnormality in vivo, then the suspicious area in the multicolor image and finally it seeing in detail on the OCT enables us to make an accurate diagnosis and timely referral.
Having the ability to take 55° wide fundus images as well as 55° OCT images puts the global health of the posterior pole into perspective and can help us catch suspicious areas in these patients with otherwise normal macular anatomy. All these images were obtained in one sitting at the same instrument (Spectralis, Heidelberg), which made patient flow easier, and further enhanced patient care by providing outstanding, clinically useful images that aided in making a diagnosis.
While I initially thought that a close look at the fovea center would be where I would find abnormalities in this patient, her central maculae were uninvolved. The presence of the peripapillary choroidal neovascular membrane was a surprise. This patient was asymptomatic, and the previous visit and scans showed no abnormalities in this area. Thus, it is imperative that we keep our eyes open to any new disease processes that patients bring with them to clinic. With this mindset and the correct instrumentation on hand in clinic, we can deliver an elevated level of care.




